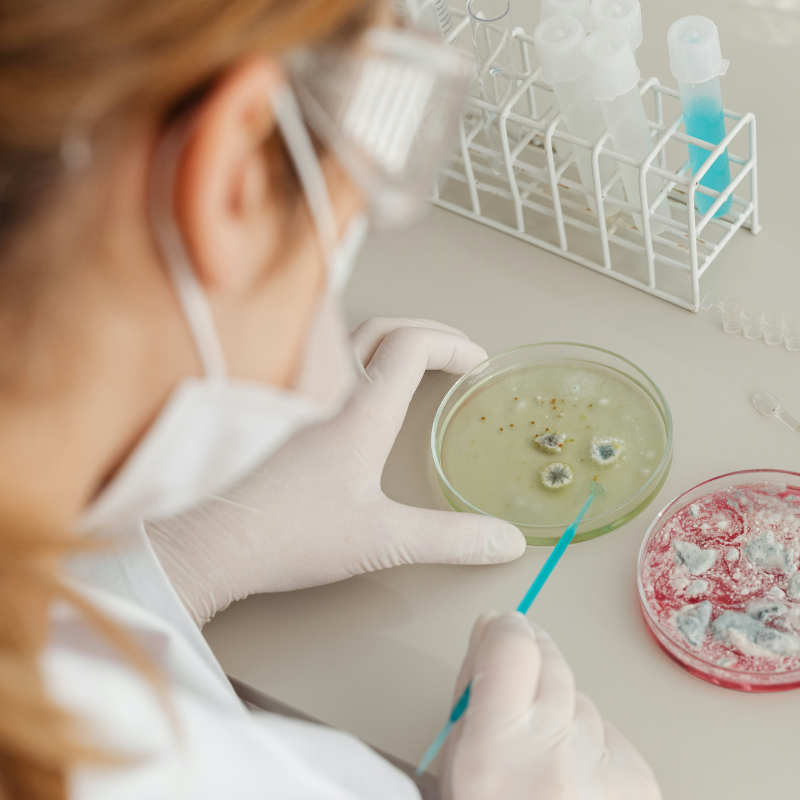

LAB-DRIVEN ROOT-CAUSE COACHING
Your stomach has been trying to tell you something. It's time to actually listen.
For women tired of managing their reflux, heartburn, and stomach pain who want real answers and lasting relief.
Stomach Reset 1:1 Coaching is a functional, lab-driven program for high-achieving women who are exhausted from managing symptoms and ready to finally find out what's driving them.
Schedule Your Strategy Session97% of clients
see a reduction in symptom intensity and severity by the end of their program
50% less cost
than most clients spend DIYing their healing with supplements, tests, and dead-end appointments
1 month
average time clients experience a significant reduction in symptoms and improvements to their health
Session 1
is all it takes for clients to feel confident and clear on their nutrition and treatment plan
*Based on outcomes reported by clients across the Stomach Reset 1:1 Coaching program.

Does this sound familiar?
You've done everything right.
You've seen the GI doctors. You've tried the elimination diets, the antacids, the pricey supplement powders.
You've Googled your symptoms at midnight more times than you can count.
And yet here you are - still dealing with the same reflux, the same heartburn, the same stomach pain - just with a longer list of things you can't eat and still no real answers.
But don't worry...
You're not broken.
You haven't been lazy.
The system you've been working within just wasn't built to uncover what's causing your symptoms. It was just built to manage those symptoms. And there's a big difference.
- You're still waking up with reflux or heartburn no matter what you eat the night before.
- You've started planning your whole life around your stomach - what you can eat, where you can go, how you'll feel.
- You want to eat without fear, show up fully for your family, and feel confident in your own body again.
- You have a gut feeling that something deeper is going on - but no one has been able to figure it out.
That all ends here.



Here's what I help women like you finally resolve for good.
➡️ Reflux, heartburn, and chronic stomach pain
➡️ GERD, gastritis, and ongoing stomach inflammation
➡️ Constipation and sluggish digestion
➡️ H. pylori overgrowth and lingering symptoms after treatment
➡️ SIBO, IBS, bloating, and food-triggered flares
➡️ Low energy and unintended weight loss
What if the thing standing between you and a calm stomach isn't another elimination diet... it's finally working with a practitioner who knows how to find what conventional medicine keeps missing?

👋 Hey, I'm Jess! I'm so glad you're here.
I’m a Functional Diagnostic Nutrition Practitioner who specializes in helping people resolve stubborn stomach symptoms like reflux, heartburn, nausea, and stomach pain - especially when nothing else has worked.
But more importantly… I’ve been exactly where you are.
For years, I lived with constant stomach discomfort, tried protocol after protocol, and kept hitting dead ends. My own journey through H. pylori, gut dysfunction, and ongoing stomach symptoms was messy, frustrating, and at times, completely overwhelming. I know what it feels like to wonder if this is just “how it’s going to be” and if you’ll ever feel normal again.
What finally changed things for me wasn’t another supplement or stricter diet... it was taking a deeper, more personalized approach to understanding what my body actually needed to heal. That process then became the foundation for how I work with my clients.
This 1:1 coaching experience exists because it’s exactly what I wish I had when I was struggling - individualized support, real answers, and a practitioner who could see the full picture and guide me through it step by step.
I combine what I learned through my own healing with years of clinical experience to help you uncover what’s driving your symptoms and create a plan your body can finally respond to.
If you're ready to stop guessing, stop managing, and start truly healing, I'd be honored to walk this path with you.
Let's do this together!
What's waiting for you on the other side.
This is what the women I work with are moving toward - and what becomes possible when we stop managing symptoms and start addressing your hidden underlying causes.

WHERE YOU ARE NOW
❌ Planning every meal around what won't trigger symptoms
❌ Waking up wondering what plans you'll have to cancel and miss out on because of your stomach
❌ Saying no to dinners out, travel, spontaneous moments
❌ Running on low energy with no clear reason why
❌ Feeling like your body is working against you

WHERE YOU'RE GOING
✅ Eating freely and confidently without fear or second-guessing
✅ Confident that you are in charge of your plans for the day, not your stomach
✅ Showing up fully present for your kids, your work, your life
✅ Having real, lasting energy that isn't contingent on your stomach
✅ Trusting your body again - because you finally understand it
Real Women. Real Results.
These previous clients weren't unicorns - they were smart, capable women just like you who took their health into their own hands and decided to dig deeper into their symptoms. And results like these are possible for you, too.
“There are so many things I could say that this program has done for me. Some of the biggest things are I've been able to eat foods that I wasn't previously able to eat. I've had more energy than I used to, less nausea and less stomach pains. And I was able to graduate from interior design school, so that's been a blessing.”
Watch Meredith describe her transformation from struggling with symptoms, not sure if she would have the energy and ability to finish interior design school, to thriving in her health and her life, as a design school graduate!
“My main concern was just getting over the daily nausea, but my pinnacle, like the very best outcome from this program that I could imagine, was eating Mexican food and drinking coffee again. Well, I'm happy to report I've done both recently and had no ill effects and it was a dream come true for a foodie like me!”
Hear Christine share how her life has changed for the better since completing the coaching program.
“I was thinking that I will never get better. I will be in these symptoms or in this feeling forever. But I'm back to myself.”
Hear Asifa’s story of finally recovering her health and life after being treated for H pylori twice with antibiotics. She went from feeling burdened that she wasn’t able to play with her kids to now feeling better than she did before treatment.
How Stomach Reset Coaching Works
This isn't a template or cookie-cutter protocol. Every step and recommendation is built around your labs, your symptoms, and your body.
Run your full functional lab panel
We start with a suite of intensive functional labs, which give us a comprehensive picture of what's happening beneath the surface to explain your symptoms that conventional testing simply doesn't look for.
Deep dive lab review
We go through your results side by side so you understand exactly what your body has been trying to tell you. This is where you finally get the answers you've been searching for. No more "your labs look fine." No more diets to cover up symptoms.

Start your custom protocol
You receive a personalized protocol built specifically around your findings — not a generic gut health template that could have been written for anyone. This protocol will address your lab results and make recommendations for the best diet, lifestyle, and mindset adjustments to enable you to reach your health goals.

Get support at bi-weekly coaching calls
We meet every two weeks to track your progress, troubleshoot, and adjust as your body responds. Healing isn't linear, and your support shouldn't be either. During these sessions, we will slowly implement the essential lifestyle strategies so that you will leave your time in the program with a foundation that supports optimal gut health for good!

Ongoing support between sessions
Email support and your private client portal keep you grounded and guided throughout the entire program, not just on call days. You don't have to wait months to talk to your practitioner. I'm on call M-F to support you in your healing journey, however you need.

Your Stomach Reset Starts Here
Two paths, one goal: getting to the root of what's been holding you back. Choose the level of support that feels right for where you are.
🧬 Genetic testing - included in Elite
Your genes don't determine your destiny, but they do reveal how your body uniquely processes nutrients, responds to stress, and detoxifies. Elite clients receive genetic testing at no additional cost, which gives us another layer of data to personalize your protocol even further and ensure we're not leaving any healing opportunities on the table.

You've been managing things for long enough.
Book a free strategy call and let's talk about what's going on, what you've already tried, and which tier of Stomach Reset Coaching is the right fit for where you are right now.
No pressure, no pitch. Just a real conversation about your gut and what's actually possible.
Schedule Your Free Call



